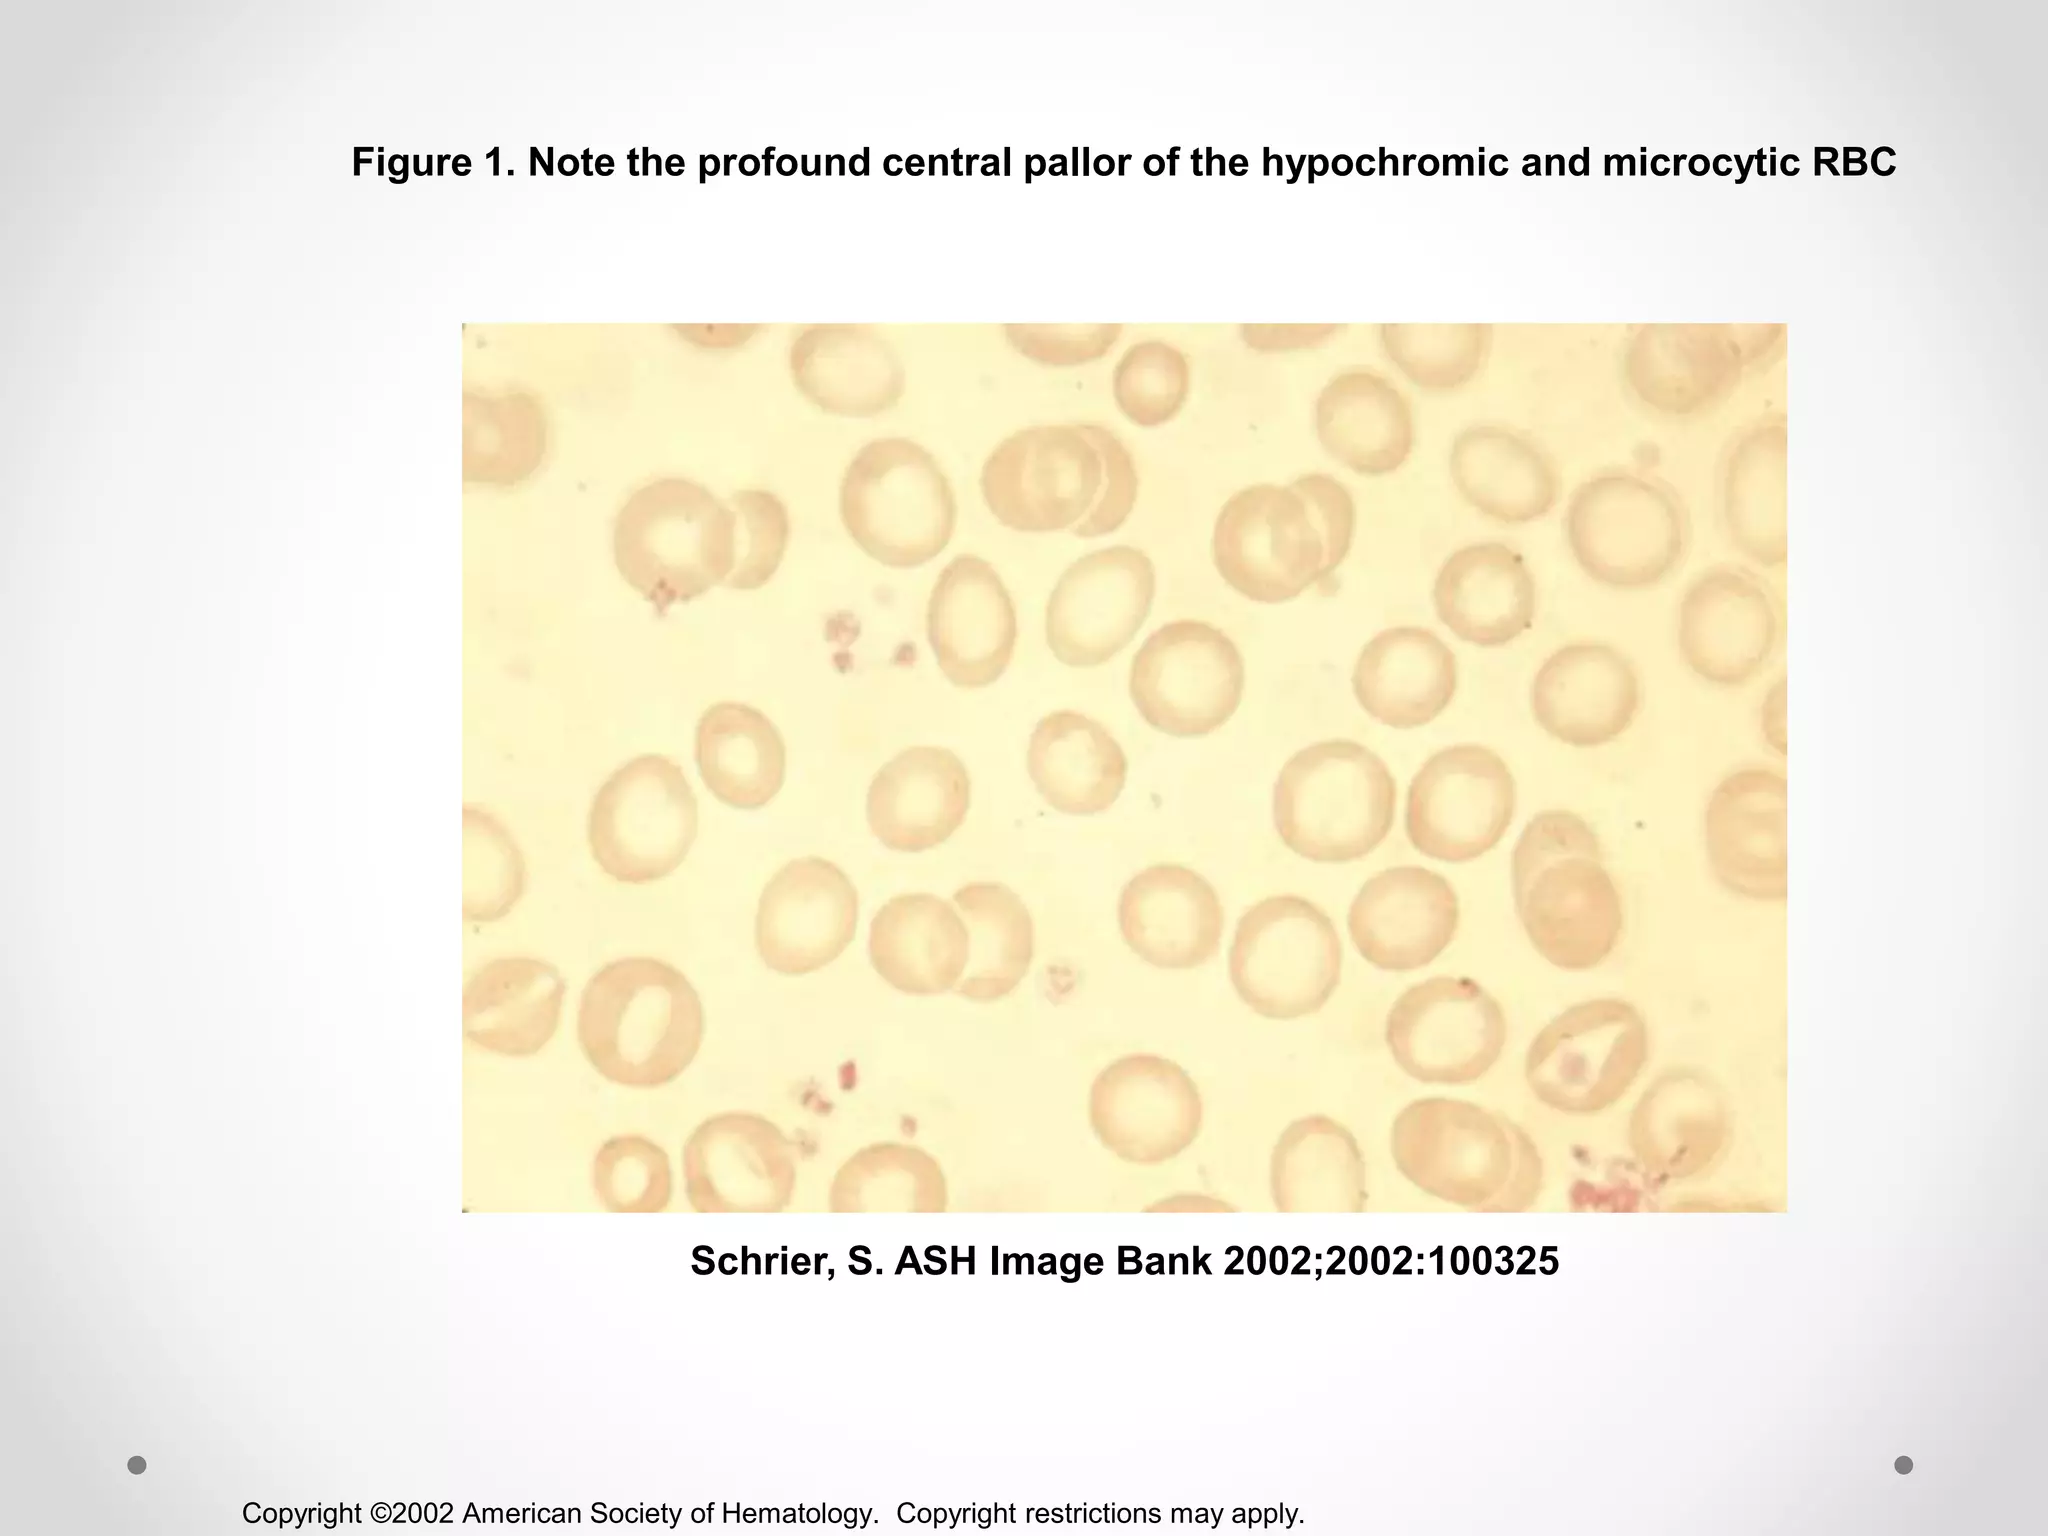
Copyright ©2002 American Society of Hematology. Copyright restrictions may apply.
Schrier, S. ASH Image Bank 2002;2002:100325
Figure 1. Note the profound central pallor of the hypochromic and microcytic RBC
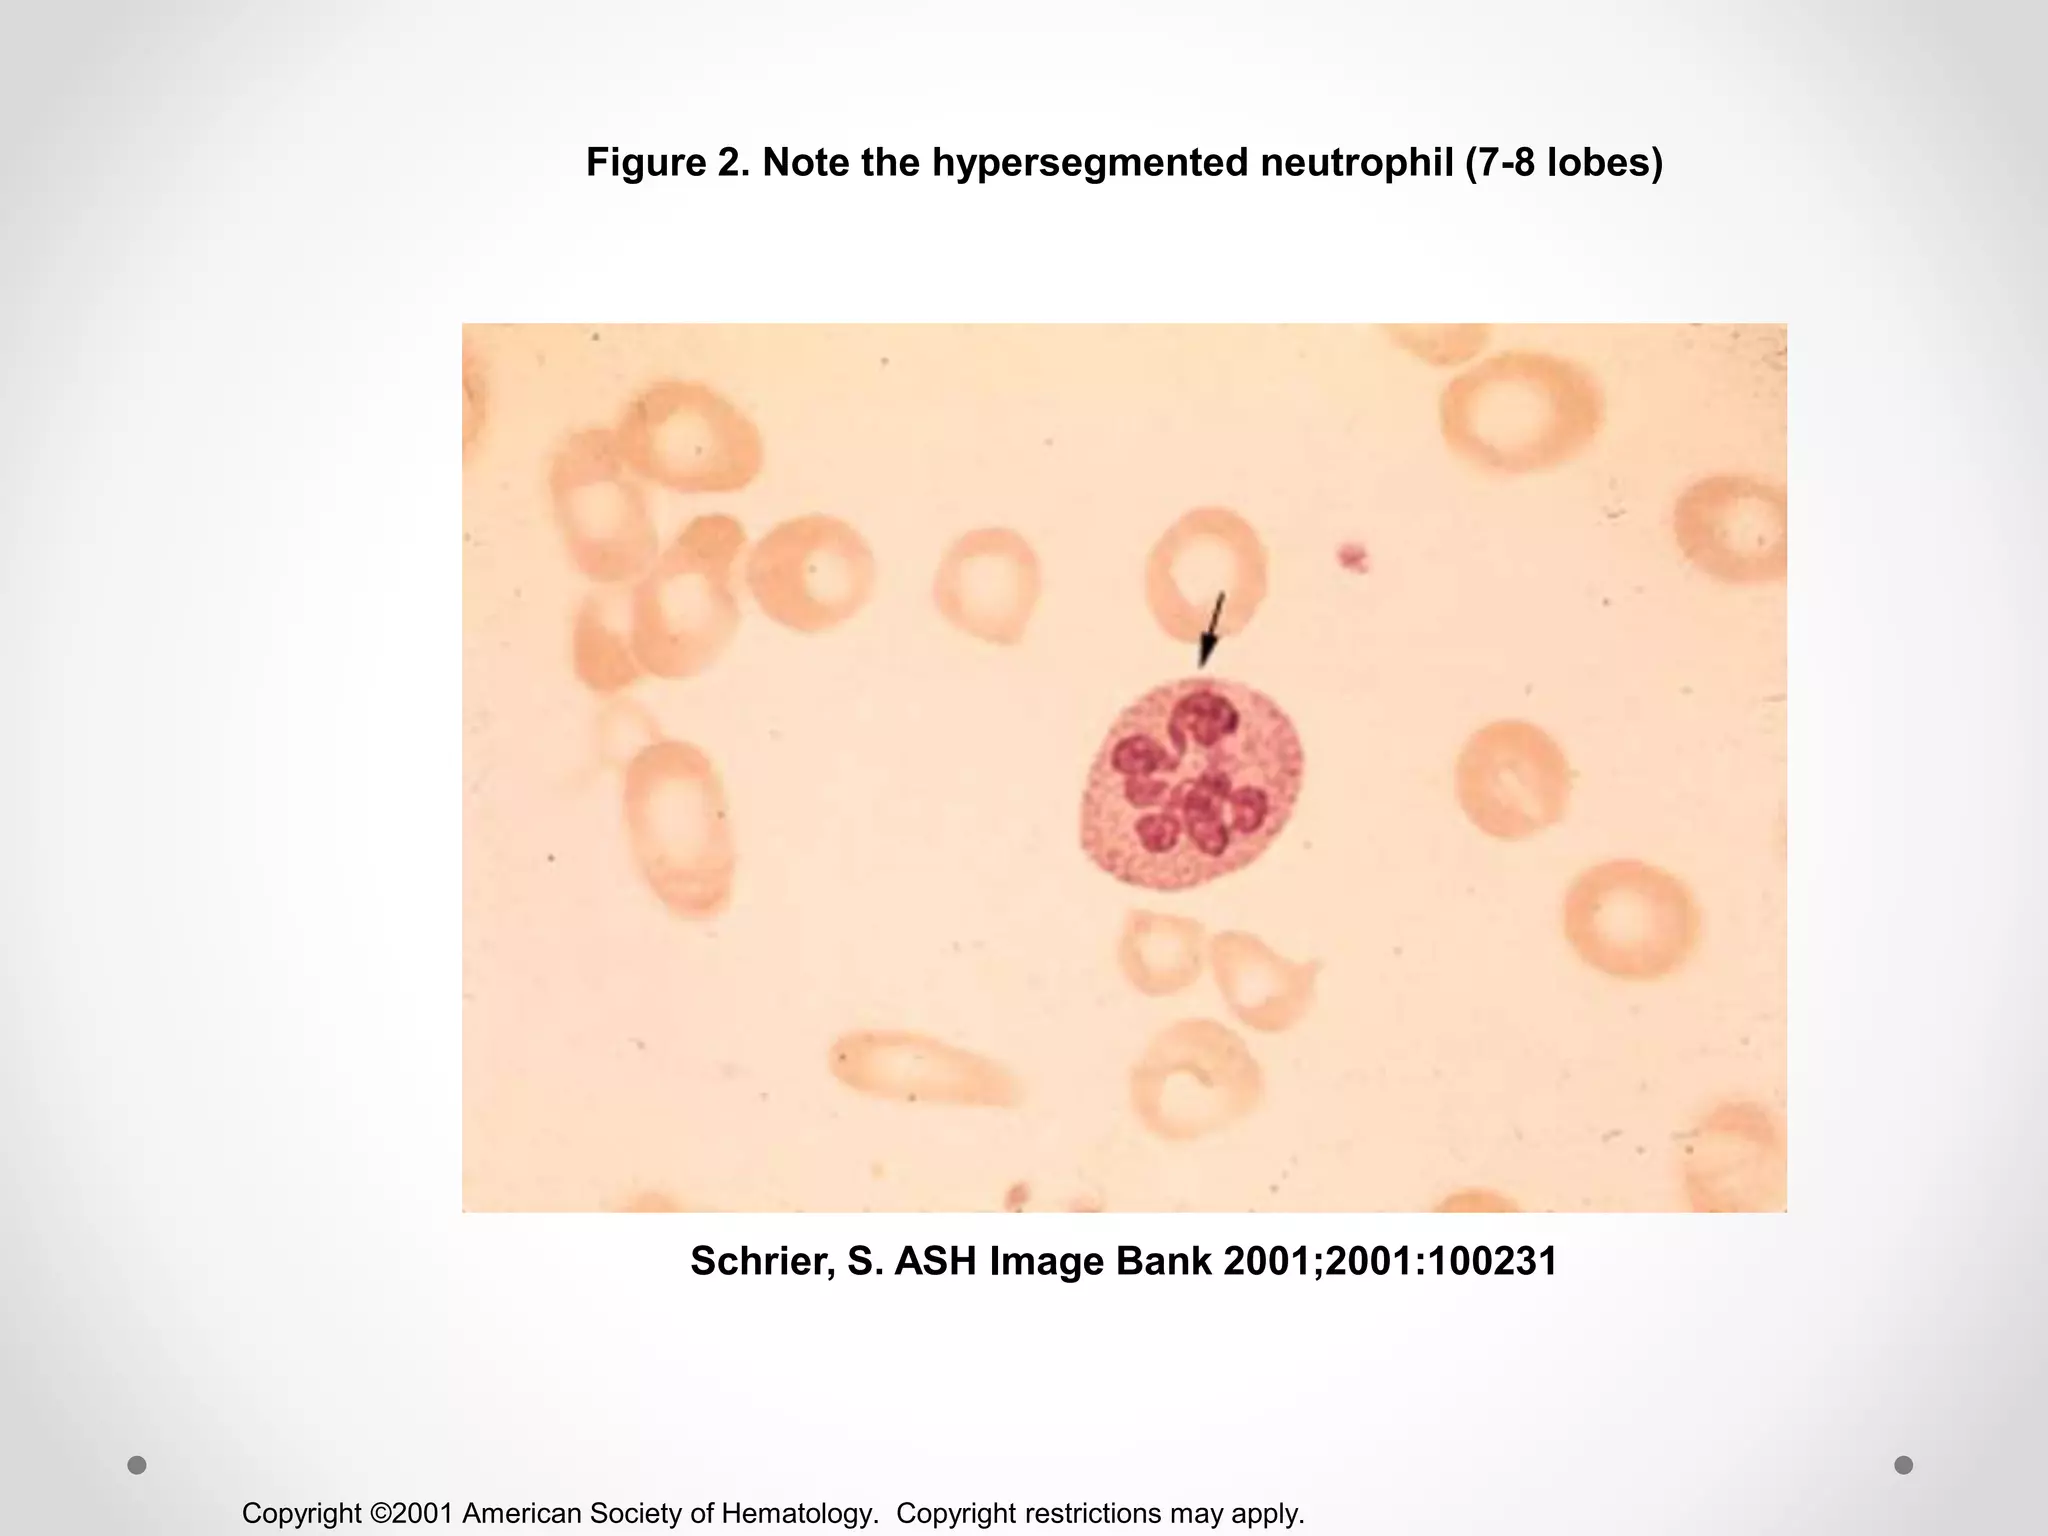
Copyright ©2001 American Society of Hematology. Copyright restrictions may apply.
Schrier, S. ASH Image Bank 2001;2001:100231
Figure 2. Note the hypersegmented neutrophil (7-8 lobes)
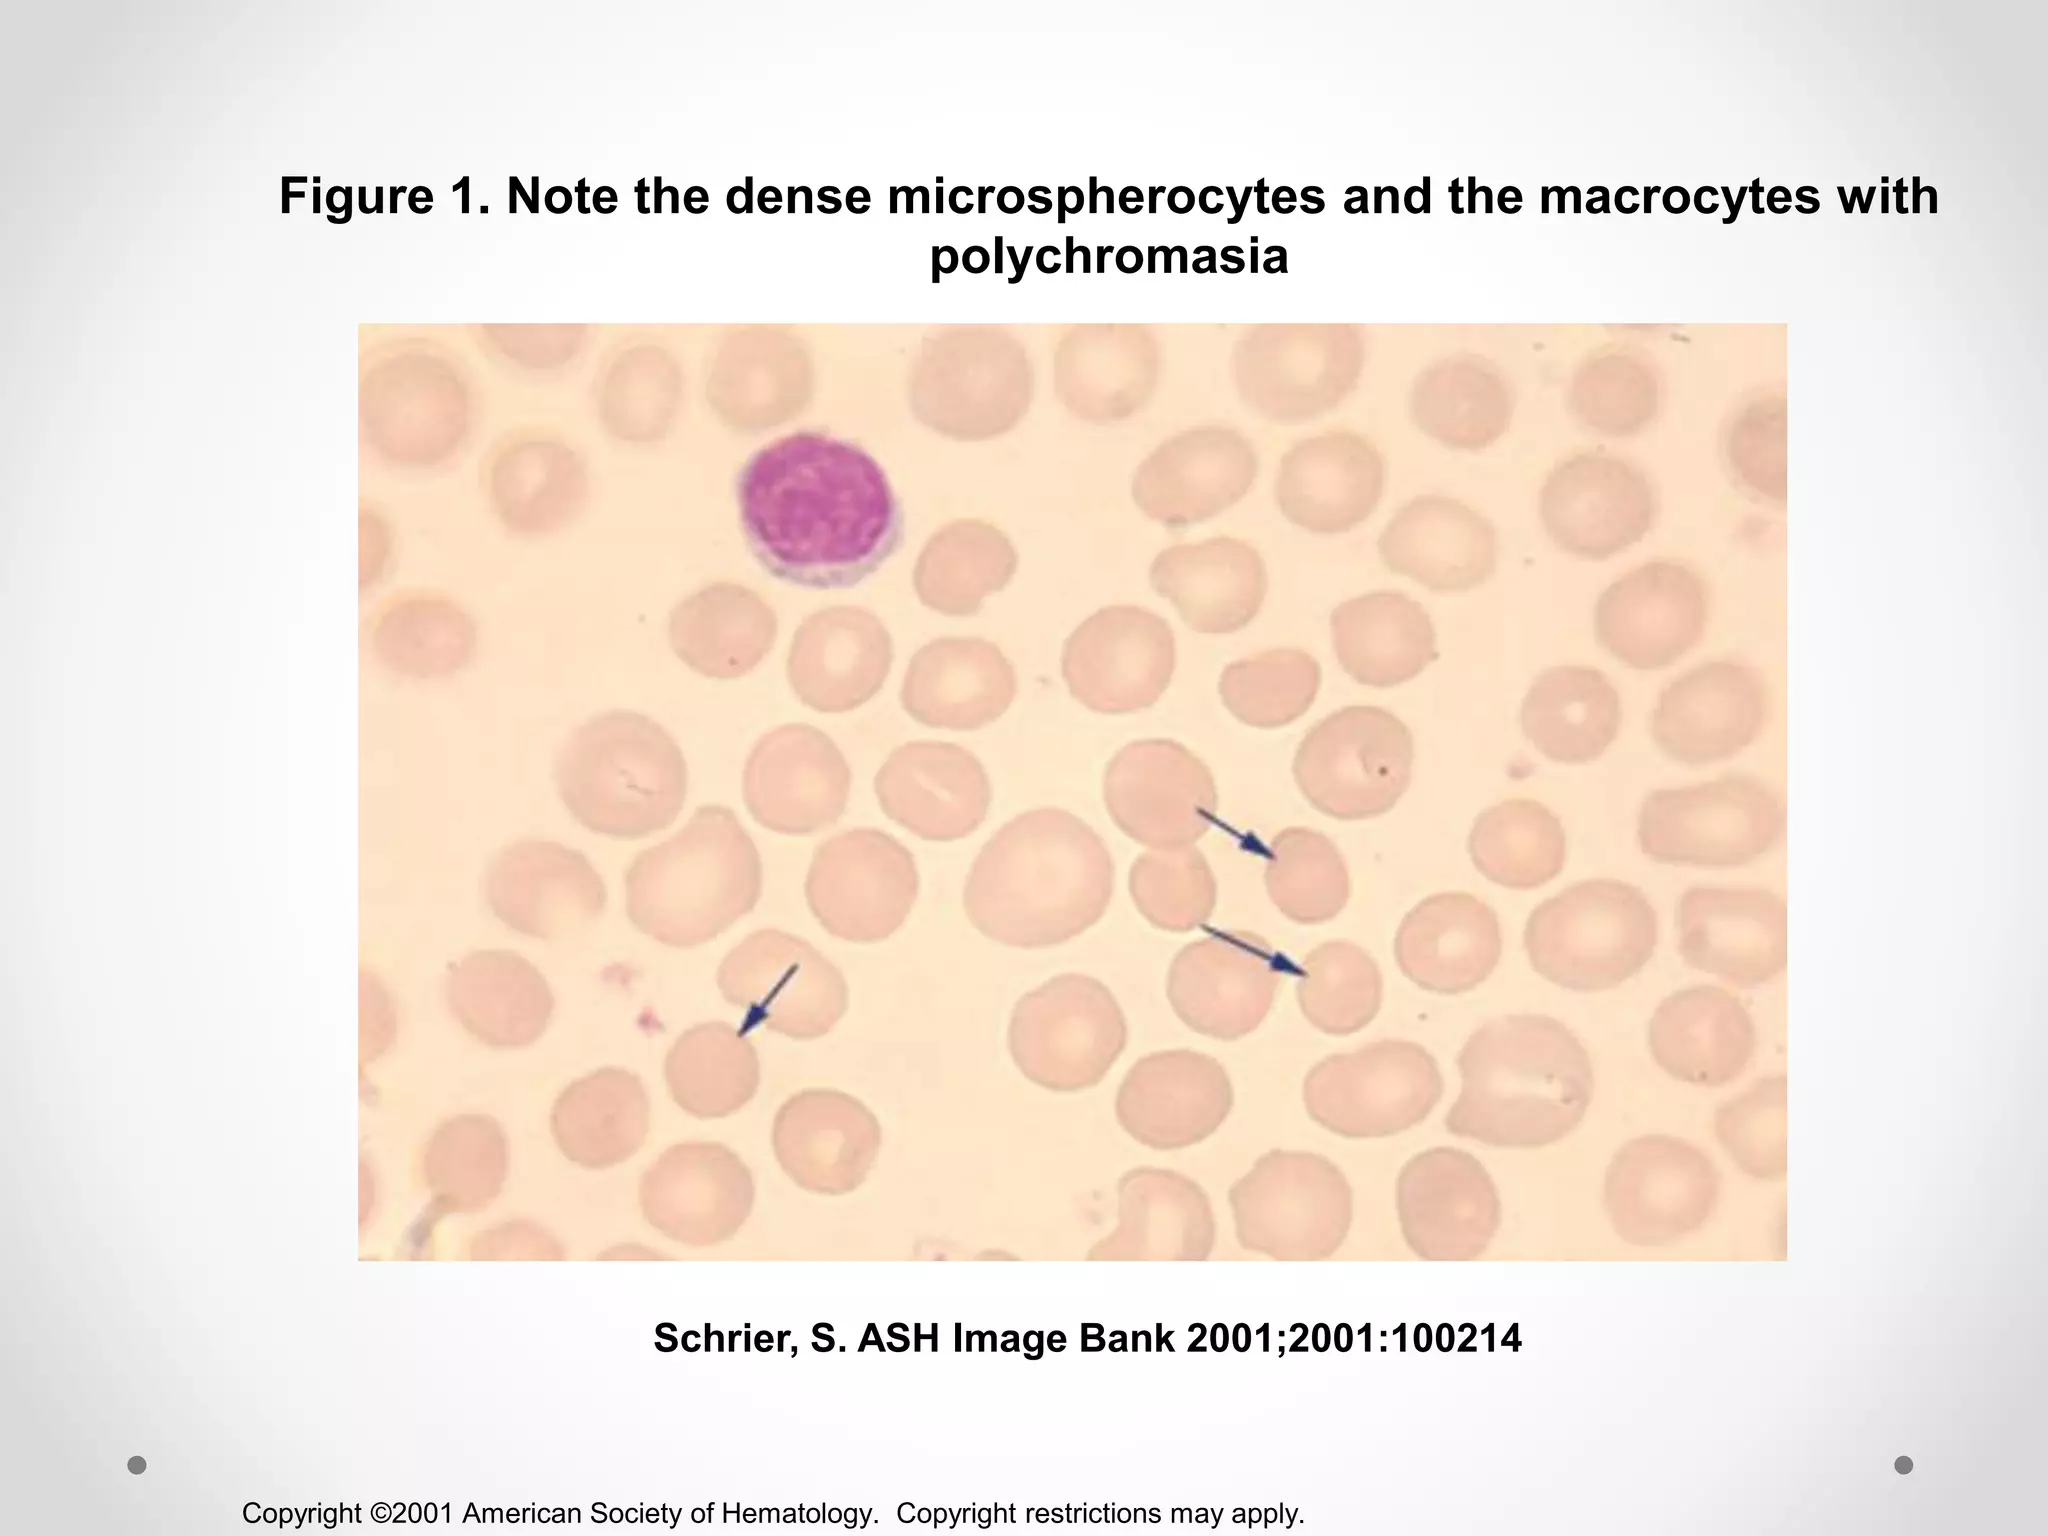
Copyright ©2001 American Society of Hematology. Copyright restrictions may apply.
Schrier, S. ASH Image Bank 2001;2001:100214
Figure 1. Note the dense microspherocytes and the macrocytes with
polychromasia
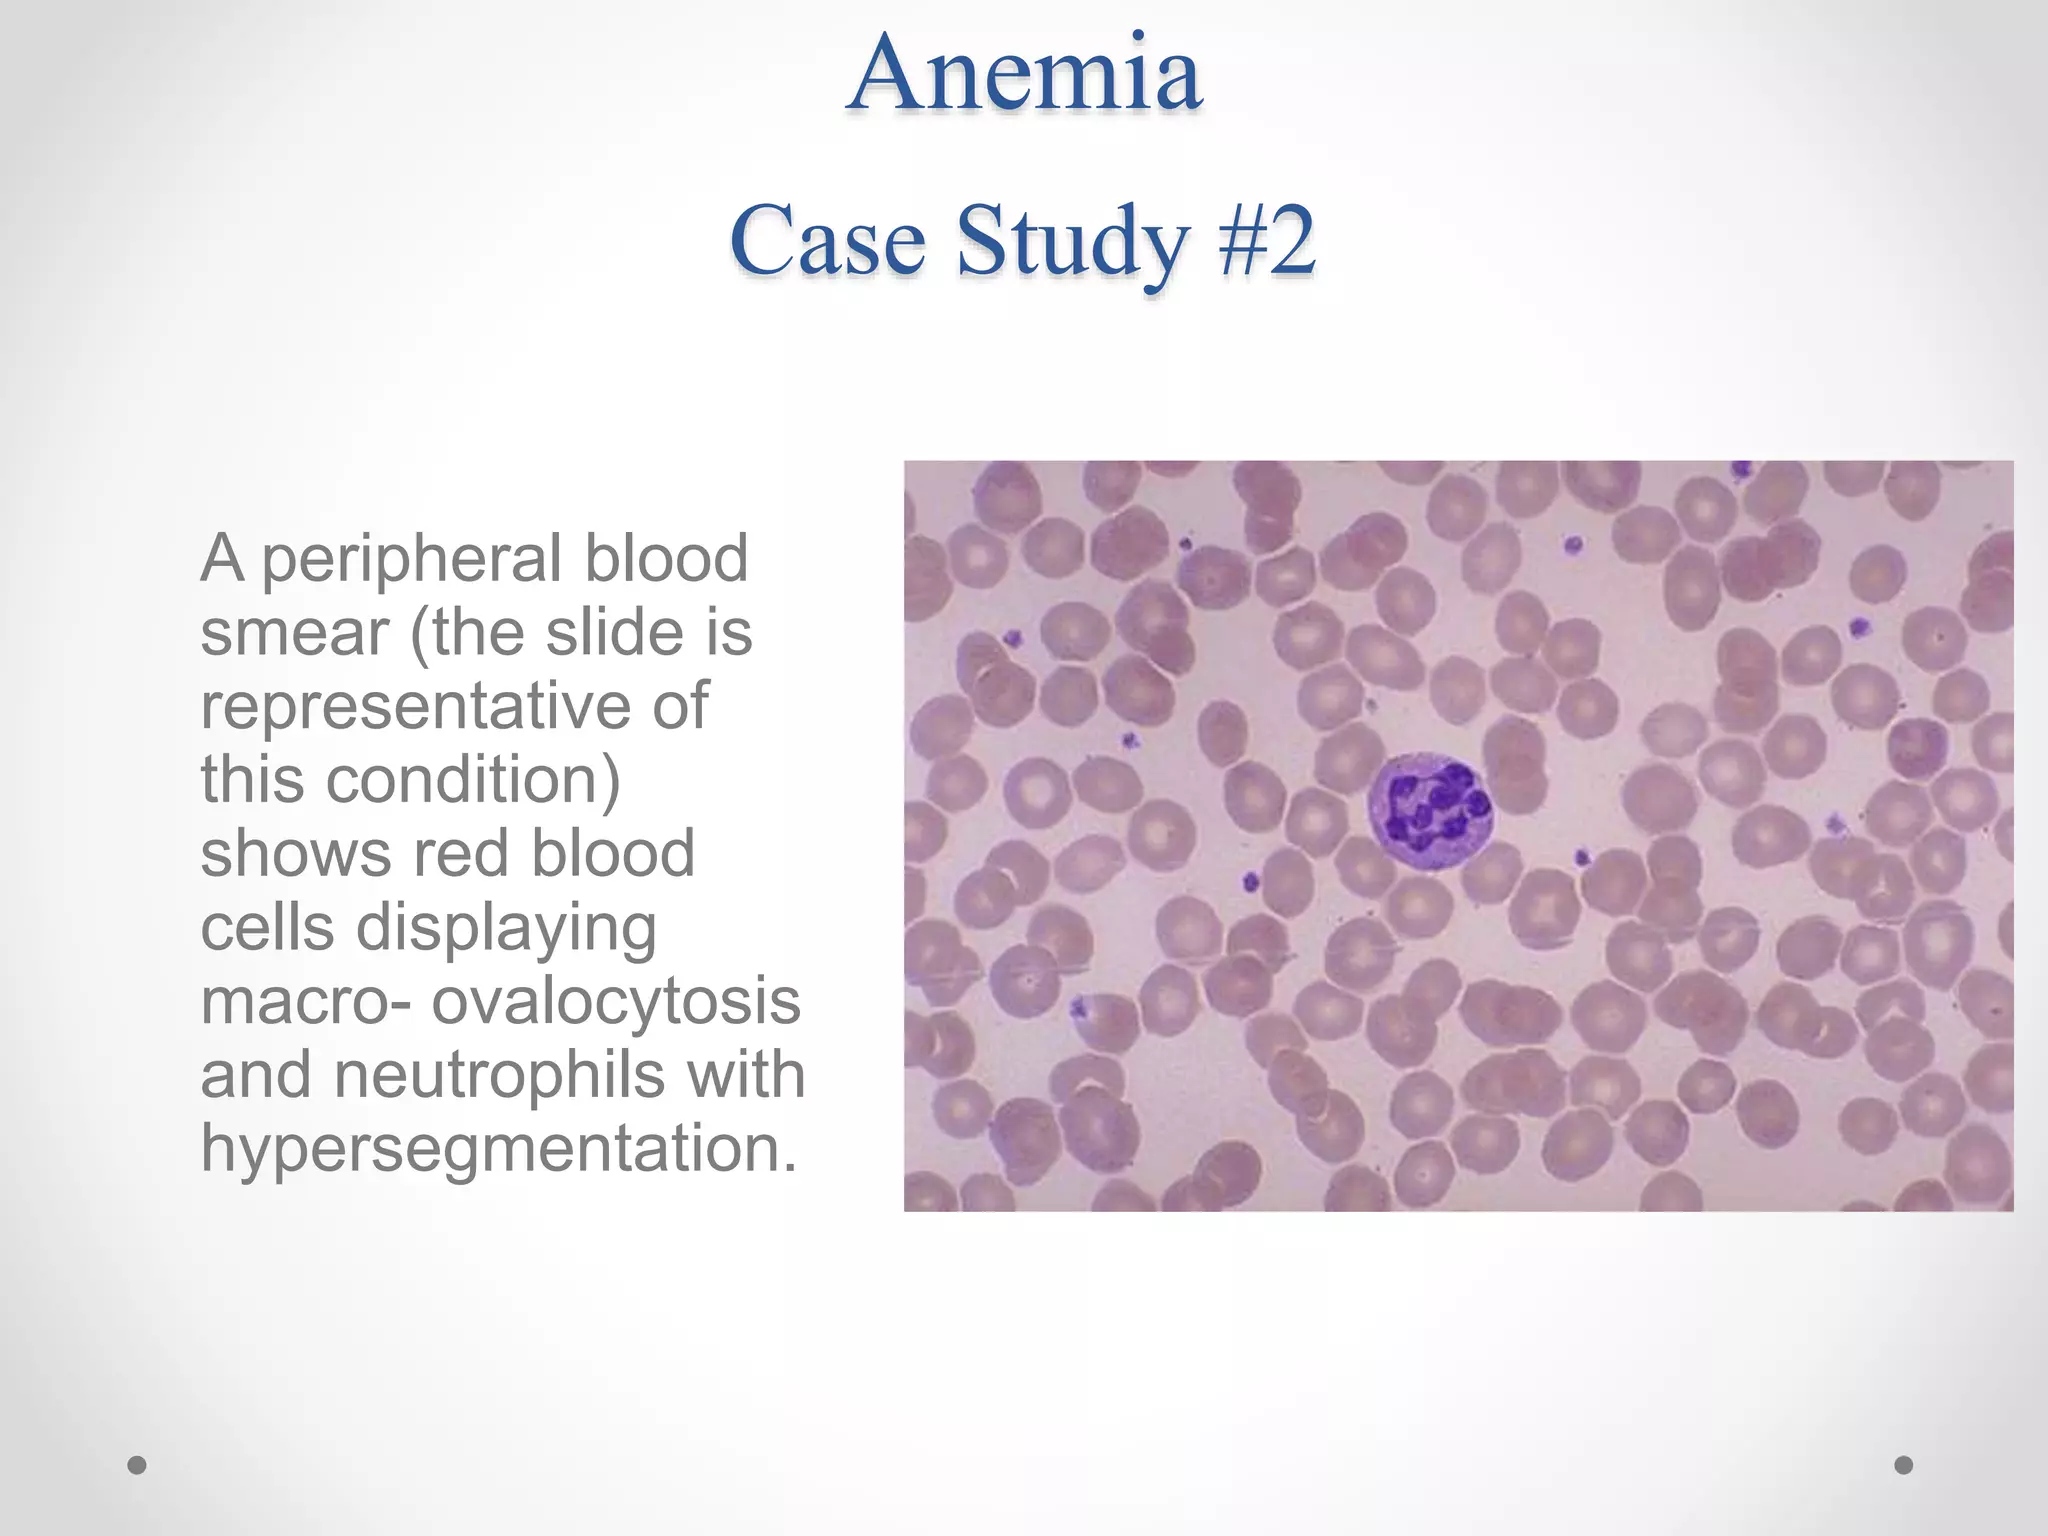
Anemia
Case Study #2
A peripheral blood
smear (the slide is
representative of
this condition)
shows red blood
cells displaying
macro- ovalocytosis
and neutrophils with
hypersegmentation.

The diagnosis is vitamin B12 deficiency (pernicious anemia).
The neurologic findings can be explained by the fact that severe B12 deficiency can damage the dorsal and lateral columns of the spinal cord, leading to decreased vibratory sense, loss of position sense in the joints, and possibly ataxia. This is because B12 is essential for myelin formation and maintenance in the nervous system.
The next step would be to measure the patient's serum B12 level and consider treatment with parenteral B12 injections if deficient.